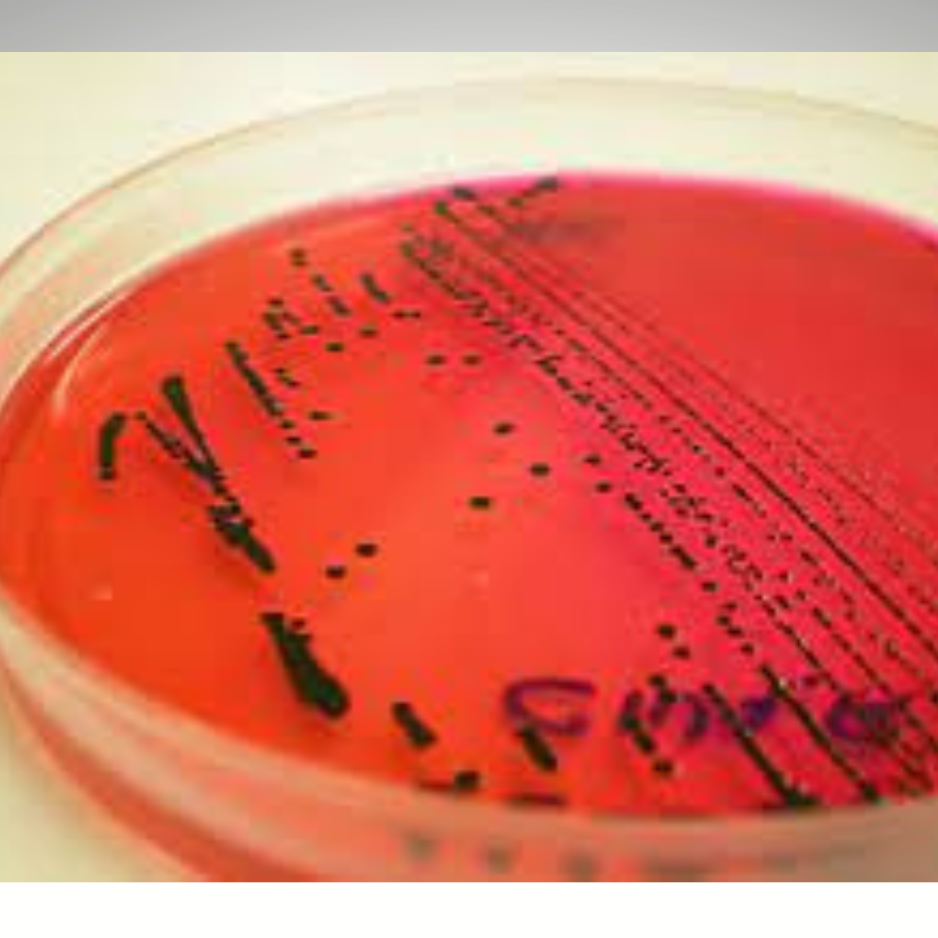

COPROCOLTURA
Esame colturale per la rilevazione di funghi e batteri patogeni nelle feci. È completo di aromatogramma.
80.00€
Aggiungi al carrelloEsame colturale delle feci
Con la coprocoltura si esegue un’esame microbiologico su campione di feci che consente la rilevazione di funghi e batteri patogeni. In caso di rilevazione di patogeni o funghi, questi vengono sottoposti ad Aromatogramma, Antibiogramma o Micogramma (in caso di funghi) così da individuare l'olio essenziale o farmaco più efficace per eliminarne la carica batterica o micotica.
Successivamente all’acquisto del test online, si riceverà il kit con tutto l’occorrente per la spedizione del campione.
La coprocoltura è un’esame compreso anche nel Gut screening normal e large.